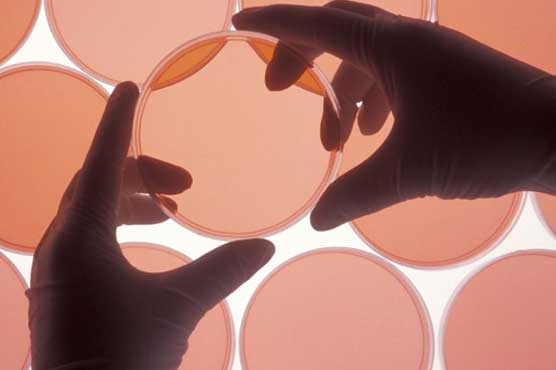
FDA Grants Seven Years' Market Exclusivity to Eagle Pharma's Ryanodex

Summary Ryanodex is a novel formulation of the antidote for management of malignant hyperthermia
WOODCLIFF LAKE (BSW) - Eagle Pharmaceuticals, Inc. ("Eagle" or "the Company") (Nasdaq:EGRX) today confirmed that the U.S. Food and Drug Administration (FDA) has granted seven years of market exclusivity in the U.S. to Ryanodex(dantrolene sodium) for Injectable Suspension for the treatment of malignant hyperthermia (MH). Ryanodex was designated an orphan drug in August 2013 and was approved by the FDA in July 2014 for this indication.
"We are very pleased that the anticipated market exclusivity for this important orphan drug has been formally granted," said Scott Tarriff, President and Chief Executive Officer. "The response to Ryanodex has been positive since its launch late last August, and we look forward to further market penetration going forward."
About Ryanodex
Ryanodex is a novel formulation of the antidote for management of malignant hyperthermia (MH), a potentially fatal disorder described in more detail below. Ryanodex is available in single-use vials containing 250mg of dantrolene sodium in lyophilized powder form. It is formulated for rapid reconstitution and administration in less than one minute to patients in malignant hyperthermia crisis. Ryanodex should be administered by continuous rapid intravenous push beginning with a loading dose of 2.5 mg/kg, and continuing until symptoms subside. Ryanodex is the first significant enhancement to the management of malignant hyperthermia in more than three decades, and has the potential to become the new standard of care in malignant hyperthermia management.
About Malignant Hyperthermia
Malignant Hyperthermia is a condition that can be triggered when genetically susceptible individuals come in contact with certain inhaled (volatile) anesthetics or the muscle relaxant succinylcholine. These patients can experience tachycardia, elevated blood pressure, raised carbon dioxide levels, and very high body temperature levels. If not treated immediately, the hypermetabolic episode can be fatal.
About Eagle Pharmaceutical, Inc.
Eagle is a specialty pharmaceutical company focused on developing and commercializing injectable products that address the shortcomings, as identified by physicians, pharmacists and other stakeholders, of existing commercially successful injectable products. The Company s strategy is to utilize the FDA s 505(b)(2) regulatory pathway. Additional information is available on the company s website at�www.eagleus.com.
Forward-Looking Statements
This press release contains forward-looking information within the meaning of the Private Securities Litigation Reform Act of 1995, as amended and other securities laws. Forward-looking statements are statements that are not historical facts. Words such as "expect(s)," "feel(s)," "believe(s)," "will," "may," "intends," "anticipate(s)," "look forward," "upcoming," "plan," "enables," "potentially," "entitles," and similar expressions are intended to identify forward-looking statements. These statements include, but are not limited to, statements regarding future market penetration of Ryanodex. All of such statements are subject to certain risks and uncertainties, many of which are difficult to predict and generally beyond the control of the Company, that could cause actual results to differ materially from those expressed in, or implied or projected by, the forward-looking information and statements. Such risks include, but are not limited to, the successful marketing of Ryanodex, and other risks described in Eagle s Annual Report on Form 10-K for the year ended September 30, 2014, and its other filings with the U.S. Securities and Exchange Commission. Readers are cautioned not to place undue reliance on these forward-looking statements that speak only as of the date hereof, and we do not undertake any obligation to revise and disseminate forward-looking statements to reflect events or circumstances after the date hereof, or to reflect the occurrence of or non-occurrence of any events.





